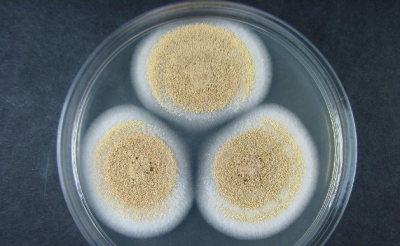

行業(yè)標配儀器
-
食品微生物學檢驗方案
2016-06-21WTO公布,全世界每年都有數(shù)億人隱食品污染而致病,近200萬兒童喪生。長期以來,我國過也出現(xiàn)了許多食品安全的問題,例如北京的福壽螺事件、武漢的人造蜂蜜事件、臺州毒豬油事件、南京“口水油”沸騰魚、上海瘦肉精中毒事件、河...
-

細胞培養(yǎng)實驗室建設方案
2016-06-21細胞學在生命科學科中起著至關重要的作用,近年來細胞學蓬勃發(fā)展,并取得了重大的進展,細胞實驗室的構建也是各個院校生物學科必備的實驗室。 細胞實驗謹慎復雜,需要的實驗設備種類繁多,下面就一些動物細胞實驗室必備儀器進行簡...


